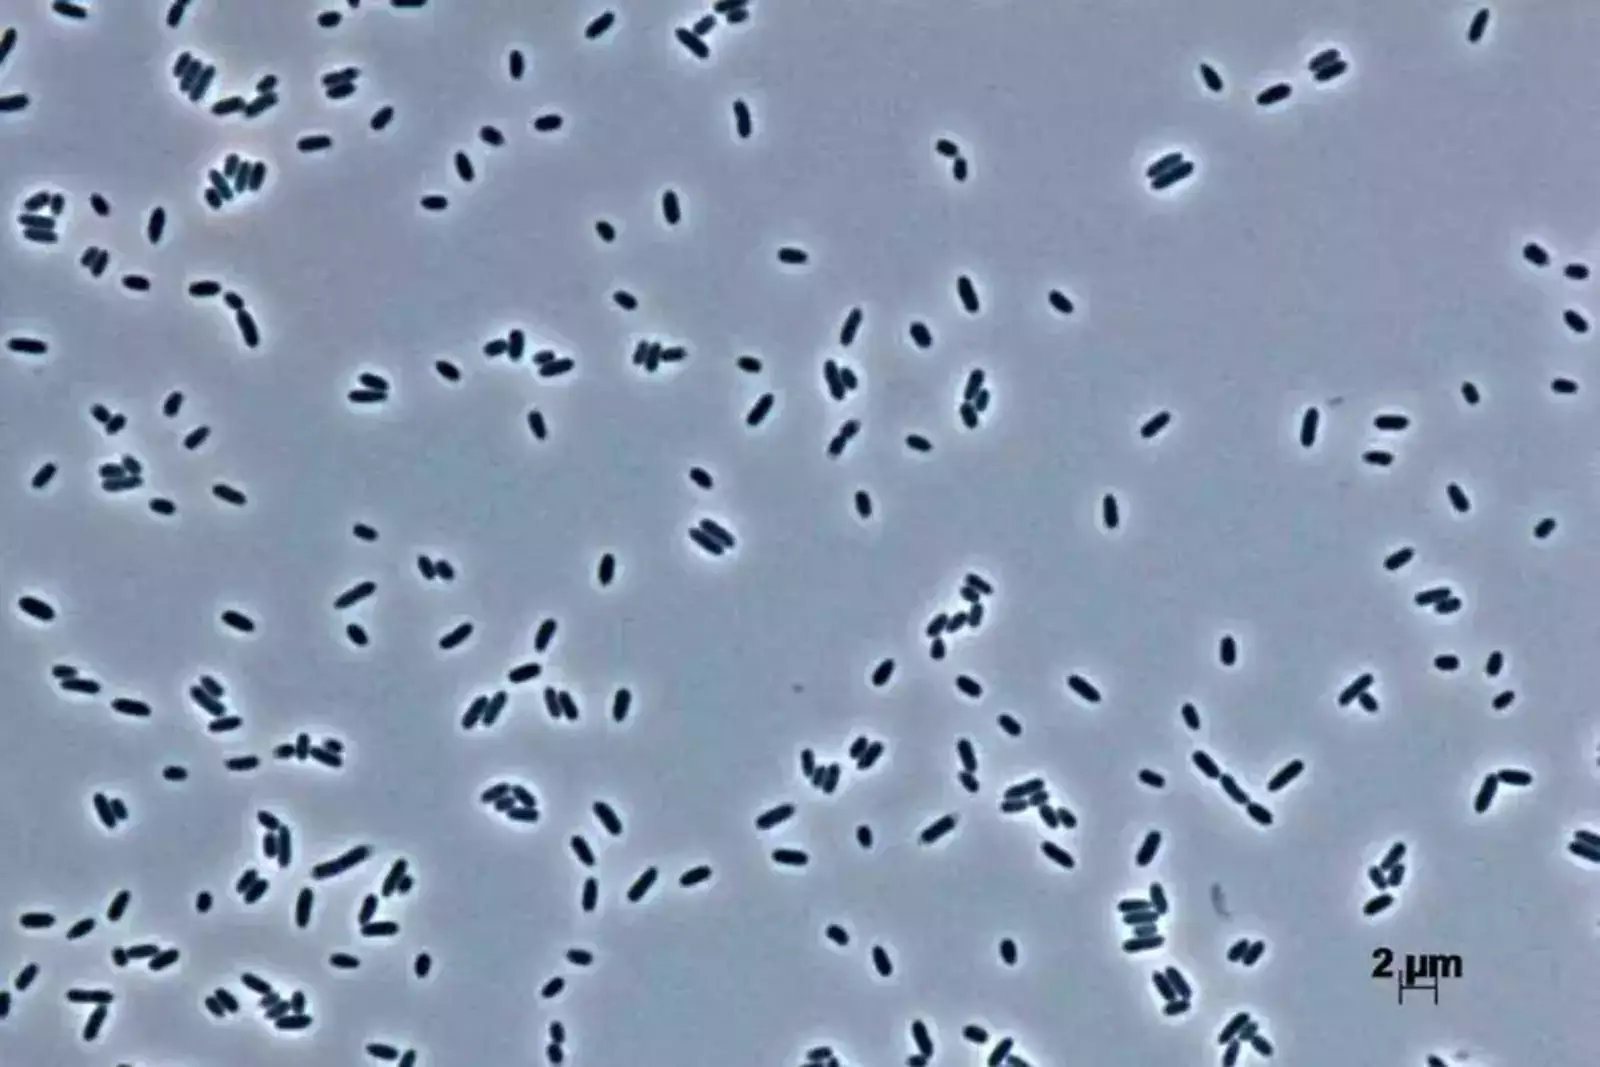

Пьер Дешелот из Университетской больницы Руана (Франция) разработал экспериментальный пробиотик, который помогает людям с избыточным весом придерживаться определённой диеты и похудеть.
Ранее пероральное введение кишечной бактерии Hafnia alvei уже было испытано на мышах с ожирением, которые снизили вес благодаря этой терапии. Теперь же препарат был испытан на людях с избыточным весом.
Пробиотик работает очень просто: он производит молекулу под названием ClpB, которая имитирует гормон альфа-МСГ, снижающий аппетит. Этим воспользовались участники эксперимента, в рамках которого 212 человек с избыточной массой тела должны были сократить потребление калорий в течение трёх месяцев. При этом половина испытуемых также принимала таблетки, содержащие новый пробиотик H. alvei.
Люди в обеих группах были одного возраста, роста и начального веса, однако среди тех, кто принимал пробиотик, 55% человек потеряли не менее 3% массы тела по сравнению с 41% участников, принимавших плацебо.
Бактерия Hafnia alvei.
Ввиду снижения веса у некоторых участников заметно снизился риск развития диабета второго типа, а также сердечно-сосудистых заболеваний. В подтверждение этого факта исследователи обнаружили, что у людей, принимавших пробиотик, уровень сахара в крови оказался значительно ниже, чем у группы плацебо.
Ежемесячные опросы показали, что люди, принимавшие H. alvei, чувствовали себя значительно более сытыми через три месяца после начала эксперимента по сравнению с другими участниками. Не исключено, что этот пробиотик в некоторой степени расщепляет жир, помогая похудеть.
Однако учёные подчёркивают, что пробиотики по-разному влияют на людей в зависимости от их генетики, кишечного микробиома и общего обмена веществ. Поэтому принимать их нужно в индивидуальном порядке и только по назначению врача, чтобы свести к минимуму побочные эффекты.